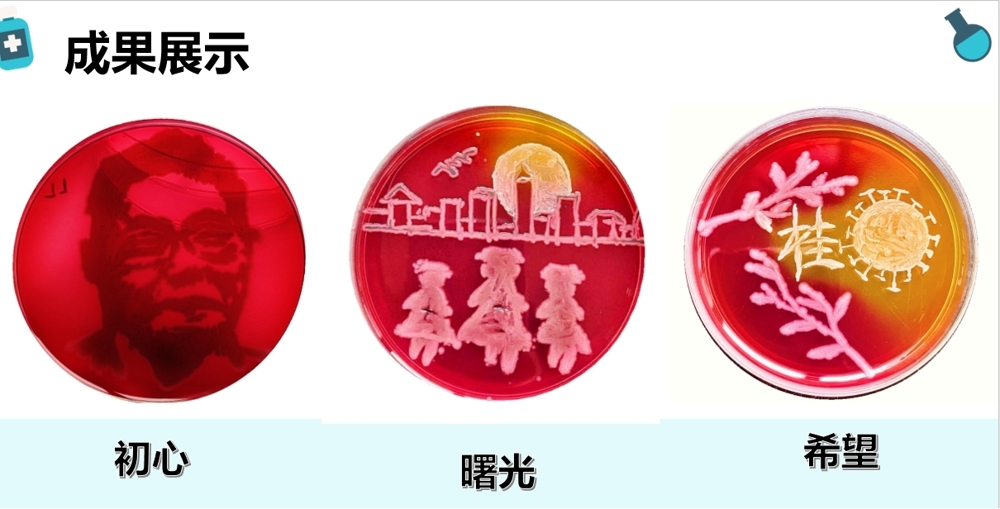
参赛作品

【喜讯】梁亮老师指导本学生参加2021年第七届全国青年科普创新实验暨作品大赛获广西赛区(复赛)一等奖
2021年4月24~25日,由自治区科协、共青团广西区委主办,广西科技馆(广西青少年科技中心)承办,广西大学生创业就业研究会、广西机械工业教育协会协办的第七届全国青年科普创新实验暨作品大赛广西赛区(复赛)在广西科技馆举办。本教研室梁亮老师指导的2019级口腔专业学生廖春燕和2018级食品质量与安全专业傅万莉同学的参赛作品《逐光》,一路披荆斩棘冲出校赛,获得广西赛区一等奖。
参赛作品

学生领奖

梁亮老师与学生合影
